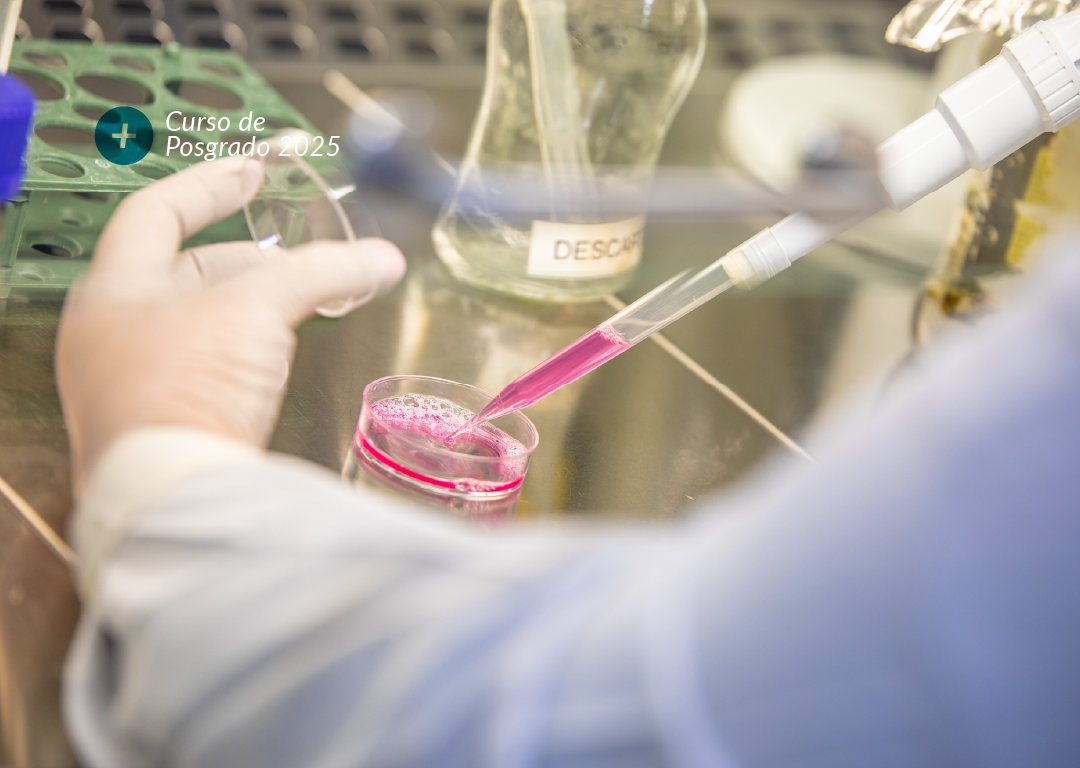

BOLETÍN INFORMATIVO N° 24 | MARZO 2025
Curso de Posgrado 2025
ENSAYO PRECLÍNICO IN VIITRO:
APLICACIONES EN BIOMEDICINA HUMANA Y VETERINARIA
Actualizar y profundizar conocimientos teóricos y prácticos sobre ensayos preclínicos in vitro, incluyendo el uso de sistemas de cultivo celular, líneas celulares y microorganismos para evaluar fármacos y bioproductos en biomedicina humana y veterinaria.
A. Contenidos y Docentes
Teórico 1
Concepto de medicina comparada – Diseño y ejecución de ensayos preclínicos.
Dr. Hugo H. Ortega. Facultad de Ciencias Veterinarias – Universidad Nacional del Litoral. Director – Centro de Medicina Comparada – Instituto de Ciencias Veterinarias del Litoral (UNL-CONICET).
Teórico 2
Diseño y ejecución de ensayos preclínicos in vitro en el CMC (Área de Ensayos in vitro)- Normativa. Métodos alternativos. Evaluación de eficacia y bio ompatibilida de fármacos y bioproductos.
Dra. María Eugenia Baravalle. Centro de Medicina Comparada – Instituto de Ciencias Veterinarias del Litoral (UNL-CONICET).
Teórico 3
Aspectos normativos nacionales e internacionales. Gestión de calidad sobre ensayos in vitro.
Dra. Natalia Salvetti; Dr.a Florencia Rey. Facultad de Ciencias Veterinarias – Universidad Nacional del Litoral Centro de Medicina Comparada – Instituto de Ciencias Veterinarias del Litoral (UNL-CONICET).
Teórico 4
Conceptos generales sobre cultivos celulares. Bioseguridad en el laboratorio de ensayos in vitro.
Dra.Belkis Marelli. Facultad de Ciencias Veterinarias – Universidad Nacional del Litoral Centro de Medicina Comparada – Instituto de Ciencias Veterinarias del Litoral (UNL-CONICET).
Teórico 5
Ciometría de Flujo: generalidades y su aplicación en ensayos preclínicos.
Dra. Maria Sol Renna. Facultad de Ciencias Veterinarias – Universidad Nacional del Litoral. Centro de Medicina Comparada – Instituto de Ciencias Veterinarias del Litoral (UNL-CONICET).
Teórico 6
Estudio de Genotoxicidad como evaluación del daño al ADN.
Dra.Maria Eugenia Baravalle. Centro de Medicina Comparada – Instituto de Ciencias Veterinarias del Litoral (UNL-CONICET).
Teórico 7
Ensayo preclínicos con cultivos microbianos.
Dra. Andrea Berengeno. Centro de Medicina Comparada – Instituto de Ciencias Veterinarias del Litoral (UNL-CONICET).
Teórico 8
Uso de ensayos in vitro en medicina veterinaria (modelos experimentales in vitro de enfermedades en bovinos/cultivos primarios/líneas celulares).
Dra. Celina Baravalle; Dra. Antonela Stassi; Dra. Aylen Amweg; Dra. Fernanda Rodríguez. Facultad de Ciencias Veterinarias – Universidad Nacional del Liutoral Centro de Medicina Comparada – Instituto de Ciencias Veterinarias del Litoral (UNL-CONICET).
Teórico 9
Métodos alternativos: irritación ocular, sensabilización dérmica (alergencidad), irritación dérmica, fototoxicidad.
Dra. María Laura Gutiérrez. Laboratorio de Métodos Alternativos, Plataforma Tecnológica EBAL. Facultad de Medicina, Universidad de Buenos Aires.
Teórico 10
Avances en la adopción y desarrollo de metodologías in vitro en el área de toxicología reproductiva.
Dra. Noelia Nikoloff. Laboratorio de Reproducción. Facultad de Ingeniería y Ciencias Agrarias, Universidad Católica Buenos Aires (FICA-UCA).
Teórico 11
Cultivos in vitro de parásitos para producción de vacunas vivas atenuadas de uso veterinario.
Dra. Carolina Thompson. EEA INTA-Rafaela. Santa Fe.
Teórico 12
Bases y aplicaciones de los cultivos 3D: implicancia en estudios preclínicos.
Dra. Mariela Bolatti Fogolín. Unidad de biología celular. Instituto Pasteur Montevideo. Uruguay.
Teórico 13
OncoPrecision: Ensayos funcionales ex vivo para la predicción personalizada de respuestas a terapias oncológicas. Tecnología de micro-avatares de pacientes.
Dr. Gerardo Gatti. OncoPrecision. Córdoba
Práctico 1
Cultivo de líneas celulares. Preparación de placas de cultivos para evaluación de citotoxicidad. Adición de sustancias de prueba.
Dra. María Eugenia Baravalle; Dra. Belkis Marelli.
Práctico 2
Evaluación de viabilidad mediante método MTT (Espectrofotometría)
Evualiación de estrés oxidativo mediante tinción con Hidroetidina (HE) y citrometría de flujo.
Dra. María Eugenia Baravalle; Dra. Belkis Marelli; Dra. MAría Sol Renna; Dra. Antonela Stassi.
Práctico 3
Evaluación de muerte celular por apoptosis/necrosis mediante la utilización de un kit de anexina V/loduro de Propidio y citometría de flujo).
Dra. Mara Eugenia Baravalle; Dra. María Sol Renna; Dra. Antonela Stassi.
Práctico 4
Evaluación de genotoxicidad (micronúcleos/cometa) Tinción y Microscopía de fluorescencia.
Dra. María Eugenia Baravalle; Dra. Antonela Stassi.
Cierre
Work Café – Intercambio de experiencias y resultados
Dra. María Eugenia Baravalle; Dra. Belkis Marelli; Dra. María Sol Renna; Dra. Antonela Stassi.
B. Información
Fecha de realización
Del 20 al 24 de octubre de 2025
Objetivos
Actualizar los conocimientos teóricos, prácticos y normativos sobre ensayos preclínicos in vitro. Actualizar las bases conceptuales sobre los diferentes tipos de sistemas y condiciones de cultivo celular. Actualizar los conocimientos teóricos y prácticos sobre el diseño y ejecución de ensayos biológicos in vitro aplicados a la biomedicina tanto humana como veterinaria. Actualizar y profundizar conocimientos sobre metodologías que utilizan líneas celulares y microorganismos para la evaluación de eficacia, biocompatibilidad y seguridad de fármacos y bioproductos. Brindar estrategias básicas para el diseño experimental considerando los aspectos de bioseguridad y sustentabilidad.
Sistema de evaluación
Examen escrito. Su aprobación otorga 3 unidades de créditos académicos (UCAs) para el Doctorado en Ciencias Veterinarias, Universidad Nacional del Litoral.
Horas totales
45 horas.
Modalidad
Teórico/práctico – Presencial
Directora del curso
Dra. María Eugenia Baravalle
Coordinadores del curso
Dra. María Sol Renna
Dra. Belkis Marelli
Lugar de realización
Centro de Medicina Comparada – Laboratorio de Biología Celular y Molecular. Instituto de Ciencias Veterinarias del Litoral (ICIVET-Litoral), Facultad de Ciencias Veterinarias. Universidad Nacional del Litoral. Esperanza, Santa Fe
Costo e inscripción
Teoría: $ 80.000 / Teoría y Práctica: $ 150.000.
Otorgamiento de becas, inscripción hasta el 6/10/25. Cupos limitados
Consultas: ensayospreclinicosiv@icivet.unl.edu.ar
La inscripción se confirmará abonando al menos el 50% a la fecha indicada.
Inscripción: https://rb.gy/i59rvt
Datos útiles
Organizan:

Auspician:

Acerca del Centro de Medicina Comparada (CMC):
El CMC está emplazado en la Facultad de Ciencias Veterinarias de la UNL, en la ciudad de Esperanza, Santa Fe y forma parte del ICiVeT Litoral, unidad ejecutora de doble dependencia de la UNL y del Consejo Nacional de Investigaciones Científicas y Técnicas (CONICET). Este Centro se constituyó a partir de 2016, en la primera entidad estatal en obtener la conformidad con las Buenas Prácticas de Laboratorio (OCDE) por parte del Organismo Argentino de Acreditación (OAA), y el primer laboratorio de ensayos nacional en certificar esta norma con alcance específico para productos farmacéuticos. En el año 2017, amplió los alcances de la conformidad a productos químicos y agroquímicos. Sumado a ello, obtuvo por parte del Instituto Argentino de Normalización y Certificación el certificado IRAM, y la certificación de calidad ISO 9001:2015, por su Sistema de Gestión de Calidad. Es importante destacar en el año 2019, el CMC obtuvo el Premio Nacional a la Calidad 2019, otorgado por la Secretaría de Gobierno de Modernización de la Nación.

Mas información en: www.cmc.unl.edu.ar
Fuente: Prensa UNL y Prensa FCV-UNL